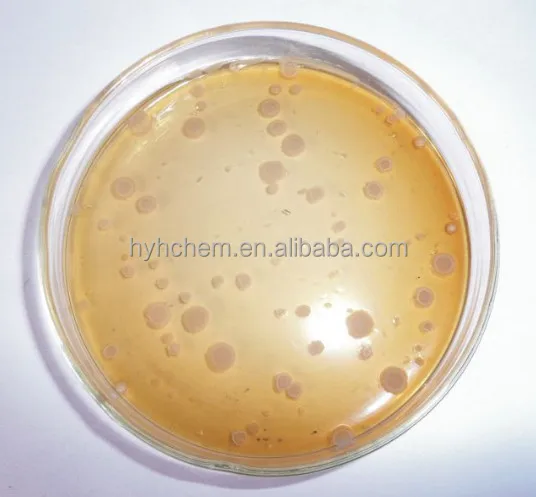

Top supplier bio agricultural fertilizer/planting/soil probiotics powder bacillus laterosporus
- Category: >>>
- Supplier: Henan Haoyuhang Economic&Trade Co. Ltd.
Share on (1600893408226):
Product Overview
Description

Bacillus laterosporus is an antagonistic bacterium with biocontrol application value in the genus Bacillus. It has high temperature resistance, strong adaptability, which can grow from 4 °C, 15-30 °C high-speed growth and reproduction, so as to effectively prevent and control diseases and enhance immunity. In addition, Bacillus laterosporus has strong resistance, adapt to pH 3.0-9.8, and it can maintain characteristics in highly polluted environments.

1.Promote plant root growth and enhance root uptake, increase crop yields;
2.Inhibit the reproduction of pathogenic bacteria in and outside plants, reduce pests and diseases, and reduce pesticide residues;
3.loosen soil and solve the phenomenon of soil compaction, activate the soil and improve fertilizer utilization;
4.Enhance plant metabolism, promote photosynthesis and strengthen leaf protective film to resist pathogenic bacteria;
5.Enhance photosynthesis, improve fertilizer utilization, and reduce nitrate content;
6.Solidify heavy metals and reduce the content of heavy metals in plants;






8.A large amount of chitinase is secreted, which can break down the cell wall of pathogenic fungi and inhibit fungal diseases;
9.Good function in decomposition of bait, feces, organic matter, etc. Bacillus laterosporus has a strong effect of cleaning up small particles of garbage in the water;
10. Improve water quality by removing the turbidity of water;
11.Reduce the occurrence of shrimp diseases, greatly increase shrimp production, and bring about economic benefits.




Regular Packaging | ||
Liquid | 200L Plastic or Iron Drum. 20L, 10L, 5L HDPE, FHDPE, CO-EX, PET Drum 1L, 500mL, 250ml 200mL, 100mL, 50mL HDPE, FHDPE, CO-EX, PET, Aluminum Foil bag, Shrink film, Measurement cap. | |
Solid | 25kg, 20kg, 10kg, 5kg, fibre drum, PP Bag, Craft Paper Bag, 1kg, 500g, 200g, 100g, 50g, 20g Aluminum Foil Bag, Soluble Bag. | |
The package can be adjusted according to customers' requirements. | ||
Delivery | ||
Size | 12 (L) * 2.1(W) * 2.23m(D) | |
Weight | 20T | |
Delivery Details | Gernerally, packed products are motor delivered from our factory to the ports in China by 20ft or 40ft containers according to customers' requirements. In addition, we can also provide air freight or express service under customers' special requests. | |



Henan Province, China. Our Group consists of four sub-companies, including one import-export company and three industrial enterprises. As a specialized organization combining Agrochemicals, Plant Growth Regulators, Fungicides, Insecticides, Herbicides, Fertilizers, Fine Chemicals, import & export trading and commercial as a whole. We have very good partner relations with many reputable chemical factories in China. Our technical team can ensure the best quality and our sales team has rich internationalbusiness experience which can help clients reduce cost and ensure the best professional service.
We have excellent production facilities and perfect checking-ways, which can sustain our powerful development and stable economic index growth. Participating in the market competition actively and being geared to international supervisor mode, our company passed ISO9001:2000 in 2003.
Our group persist in the policy of "Striving for the survival and the development by the quality control" in order to satisfy the needs of customers, which is the direction & target. To win mutual benefit is our desire, we are ready to cooperate and go forward with our friends hand inhand, and start a splendid future together! Warmly welcome customers all over the world to have a good cooperation with us in all kinds of forms and we promise you the most satisfactory services.



1. Who we are?
HYH Trade Company of HYH Group, we are located in Henan province, China, starting from 2016, selling products to North America(40.00%), Western Europe(9.00%), South America(9.00%), Eastern
Europe(8.00%), Africa(8.00%), Southeast Asia(8.00%), South Asia(5.00%), Eastern Asia(5.00%), Mid East(5.00%), Oceania(3.00%). There are about 30 sales elites in our office.
2. How can we guarantee quality?
A pre-production sample will be sent to customer before mass production, and we have final inspections before shipment.
3.What can you buy from us?
Plant growth regulators, Insecticides, Fungicides, Bio pesticides, Rodenticides.
4. Why do you choose us regardless of other suppliers?
We HYH Group consists of four sub-companies, including one import-export company and three industrial factories. As a specialized organization combining Agrochemicals, Plant Growth Regulators, Fungicides, Insecticides, Herbicides, Fertilizers, Fine Chemicals.
5. What services can we provide?
Accepted Delivery Terms: FOB, CFR, CIF, EXW, FAS, CIP, FCA, CPT, DEQ, DDP, DDU, Express Delivery, DAF, DES.
Accepted Payment Currency: USD, EUR, JPY, CAD, AUD, HKD, GBP, CNY, CHF.
Accepted Payment Type: T/T, L/C, D/P, D/A, MoneyGram, Credit Card, PayPal, Western Union, Cash, Escrow.
Language Spoken: English, Chinese, Spanish, Japanese, Portuguese, German, Arabic, French, Russian, Korean, Hindi, Italian.

We Recommend
New Arrivals
New products from manufacturers at wholesale prices




















